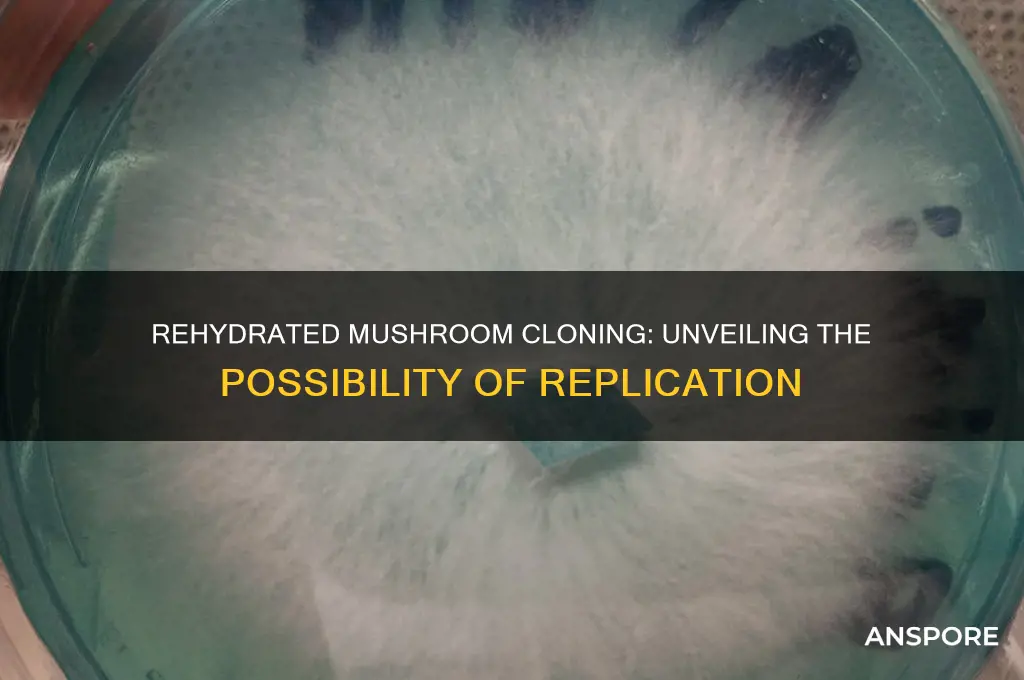
can you clone a rehydrated mushroom

The concept of cloning rehydrated mushrooms has sparked curiosity among mycologists and enthusiasts alike, as it bridges the gap between culinary practices and scientific experimentation. Rehydrated mushrooms, typically dried for preservation, regain their texture and moisture when soaked in water, raising questions about their biological viability for cloning. Cloning involves propagating an organism from a single cell or tissue sample, and while mushrooms are commonly cultivated through spores or mycelium, the idea of using rehydrated mushrooms as a source material presents unique challenges. Factors such as the viability of cells after dehydration, the presence of contaminants, and the mushroom’s genetic integrity post-rehydration must be considered. Exploring this topic not only sheds light on the resilience of fungal organisms but also opens avenues for innovative cultivation methods and sustainable food production.
Explore related products
What You'll Learn
- Rehydration Techniques: Methods to properly rehydrate mushrooms for cloning experiments
- Tissue Culture Basics: Using rehydrated mushroom tissue for lab-based cloning processes
- Sterilization Steps: Ensuring rehydrated mushrooms are sterile before cloning attempts
- Mycelium Growth: Observing mycelium development from rehydrated mushroom samples
- Success Rates: Analyzing cloning success rates with rehydrated versus fresh mushrooms

Rehydration Techniques: Methods to properly rehydrate mushrooms for cloning experiments
Rehydrating mushrooms is a delicate process that can significantly impact their viability for cloning experiments. The goal is to restore the mushroom’s cellular structure without introducing contaminants or causing degradation. Cold water rehydration is a widely recommended method, involving soaking dried mushrooms in distilled water at 4°C for 12–24 hours. This slow process minimizes osmotic shock and preserves mycelial integrity. Avoid using tap water, as chlorine and minerals can inhibit growth. For faster results, a warm water bath at 40–50°C for 15–30 minutes can be employed, but monitor closely to prevent overheating, which can denature proteins essential for cloning.
The choice of rehydration technique depends on the mushroom species and the cloning method. For instance, oyster mushrooms (*Pleurotus ostreatus*) respond well to cold water rehydration, while shiitake (*Lentinula edodes*) may benefit from a brief warm soak followed by a cold rinse. After rehydration, gently blot excess moisture with sterile paper towels to prevent dilution of nutrients during the cloning process. Always sterilize tools and containers to maintain aseptic conditions, as contamination at this stage can render the experiment futile.
A comparative analysis of rehydration methods reveals that cold water rehydration yields higher success rates in cloning experiments, particularly for delicate species. However, warm water rehydration can be advantageous when time is a constraint, provided the temperature is carefully controlled. An emerging technique involves rehydrating mushrooms in a nutrient-rich solution, such as a diluted potato dextrose broth, which can enhance mycelial vigor. This method, though promising, requires further research to optimize nutrient concentrations and pH levels.
Practical tips for successful rehydration include using airtight containers to prevent airborne contaminants and labeling samples with rehydration duration and method for consistency. For researchers, maintaining a detailed log of rehydration conditions and cloning outcomes can help identify patterns and refine protocols. While rehydration is a critical step, it is just one part of the cloning process; subsequent steps like agar inoculation and incubation must also be meticulously executed to ensure success. With the right technique, rehydrated mushrooms can indeed serve as viable candidates for cloning experiments.
Cream-Free Mushroom Sauce: A Delicious, Dairy-Free Recipe Alternative
You may want to see also

Tissue Culture Basics: Using rehydrated mushroom tissue for lab-based cloning processes
Rehydrated mushroom tissue offers a unique substrate for lab-based cloning processes, leveraging the resilience and regenerative capacity of fungal mycelium. Unlike fresh tissue, rehydrated material often undergoes cellular stress during dehydration, which can affect viability. However, with proper rehydration techniques—such as using sterile distilled water or nutrient-rich solutions at room temperature for 24–48 hours—the tissue can regain metabolic activity, making it suitable for cloning. This method is particularly useful for preserving rare or endangered mushroom species, as dried tissue can be stored long-term and reactivated when needed.
To initiate the cloning process, sterilize rehydrated mushroom tissue using a 70% ethanol solution for 30 seconds, followed by three rinses in sterile water to remove contaminants. Transfer the sterilized tissue to a nutrient-rich medium, such as potato dextrose agar (PDA) supplemented with 1% activated charcoal to inhibit bacterial growth. Incubate the culture at 22–25°C under dark conditions, as light can inhibit mycelial growth. Within 7–14 days, healthy mycelium should colonize the medium, indicating successful cloning. Regular monitoring for contamination is critical, as rehydrated tissue may carry dormant microbes that become active post-rehydration.
One of the challenges in using rehydrated tissue is the potential loss of genetic integrity due to dehydration-induced cellular damage. To mitigate this, employ molecular techniques like PCR to verify the genetic stability of cloned cultures. Additionally, compare growth rates and morphological characteristics of clones derived from rehydrated tissue to those from fresh tissue to ensure consistency. For species with slow growth rates, such as *Hericium erinaceus*, consider adding 0.1% vitamin B1 to the medium to enhance mycelial vigor.
Persuasively, this method not only preserves biodiversity but also streamlines the production of mushrooms with medicinal or culinary value. For instance, rehydrated tissue from *Ganoderma lucidum* can be cloned to produce consistent batches of mycelium for extracting bioactive compounds like triterpenes. By mastering this technique, researchers and cultivators can reduce reliance on fresh tissue, which is often seasonally limited or geographically restricted. The scalability of lab-based cloning also positions it as a sustainable solution for meeting global demand for functional mushrooms.
In conclusion, cloning rehydrated mushroom tissue is a viable and efficient technique when executed with precision. Key steps include proper rehydration, sterilization, and optimized culture conditions. While challenges like genetic stability and contamination exist, they can be addressed through rigorous protocols and molecular validation. This approach not only advances scientific research but also unlocks practical applications in agriculture, medicine, and conservation, making it a valuable tool for anyone working with fungal systems.
Inoculating Wild Trees with Mushrooms: A Woodland Mycorrhizal Guide
You may want to see also

Sterilization Steps: Ensuring rehydrated mushrooms are sterile before cloning attempts
Rehydrated mushrooms, while convenient, pose a unique challenge for cloning due to their increased susceptibility to contamination. The rehydration process itself can introduce microorganisms, making sterilization a critical step before any cloning attempt. Without proper sterilization, bacteria, fungi, or other contaminants can outcompete the mushroom mycelium, leading to failed cloning efforts or the growth of undesirable organisms.
Understanding this risk is the first step in ensuring the success of your mushroom cloning project.
The sterilization process for rehydrated mushrooms requires a multi-step approach. Begin by thoroughly rinsing the mushrooms in distilled water to remove any surface debris. Next, prepare a sterilization solution. A common and effective method involves using a 10% bleach solution (1 part bleach to 9 parts water). Submerge the mushrooms in this solution for 10-15 minutes, ensuring complete coverage. This step targets a broad spectrum of microorganisms. After bleaching, rinse the mushrooms thoroughly with sterile distilled water at least three times to remove any bleach residue, which can be harmful to the mycelium.
For a more natural approach, some cultivators use a hydrogen peroxide solution (3% concentration) for 10 minutes, followed by a thorough rinse with sterile water.
While the above methods are effective for surface sterilization, ensuring the internal sterility of rehydrated mushrooms is more complex. Unlike fresh mushroom tissue, rehydrated mushrooms may have absorbed contaminants during the rehydration process. To address this, some advanced techniques involve pressure cooking the mushrooms at 15 psi for 30 minutes. This method, while effective, carries the risk of damaging the mushroom tissue and should be approached with caution. It's crucial to experiment with smaller batches and closely monitor the process to find the optimal sterilization time and pressure for your specific mushroom species.
Remember, the goal is to eliminate contaminants without compromising the viability of the mushroom tissue for cloning.
Even with meticulous sterilization, contamination can still occur. Therefore, it's essential to work in a clean environment and use sterile tools throughout the cloning process. Utilize a laminar flow hood or a still air box to create a sterile workspace. Flame-sterilize all tools, such as scalpels and tweezers, before handling the mushrooms. Additionally, consider using agar plates to isolate and cultivate the mushroom mycelium before transferring it to a growth medium. This allows you to visually inspect for contamination and select healthy mycelium for further propagation.
By following these sterilization steps and maintaining a sterile environment, you significantly increase the chances of successfully cloning rehydrated mushrooms. Remember, patience and attention to detail are key. Don't rush the process, and be prepared to troubleshoot and adapt your techniques as needed. With careful planning and execution, you can overcome the challenges of working with rehydrated mushrooms and unlock the potential for successful cloning.
Where to Buy Single-Serve Mushroom Coffee Bags: A Quick Guide
You may want to see also
Explore related products

Mycelium Growth: Observing mycelium development from rehydrated mushroom samples
Rehydrated mushrooms, often used in culinary applications, retain viable mycelium fragments capable of regenerating under optimal conditions. When submerged in sterile water at 20-25°C for 12-24 hours, these fragments reawaken, offering a unique opportunity to observe mycelial growth. This process hinges on the mushroom’s resilience; species like *Shiitake* (*Lentinula edodes*) and *Oyster* (*Pleurotus ostreatus*) show higher success rates due to their robust mycelial networks. To initiate growth, transfer a small piece of the rehydrated mushroom (5-10 mm) to a nutrient-rich substrate, such as agar or grain spawn, ensuring sterility to prevent contamination.
Analyzing the growth stages reveals a fascinating progression. Within 3-5 days, primordial hyphae emerge, forming a white, thread-like network. By day 7-10, the mycelium colonizes the substrate, visible as a dense, cotton-like mat. This phase is critical; maintain humidity at 60-70% and temperature at 22-25°C to support expansion. Comparative studies show that rehydrated samples grow 20-30% slower than fresh tissue, likely due to cellular stress during dehydration. However, with patience, the mycelium can fully recover, demonstrating the mushroom’s latent regenerative potential.
For enthusiasts seeking to clone rehydrated mushrooms, precision is key. Sterilize all equipment using a 10% bleach solution or 70% isopropyl alcohol to eliminate competitors. Inoculate the substrate with a single, healthy fragment, avoiding over-saturation. Monitor daily for contamination, such as mold or bacterial growth, which can halt progress. A persuasive argument for this method lies in its sustainability: cloning from rehydrated mushrooms reduces reliance on fresh tissue, making it an eco-friendly alternative for mycologists and hobbyists alike.
Descriptively, the mycelium’s transformation is a testament to nature’s ingenuity. Under magnification, the network resembles a labyrinth, with individual hyphae branching and fusing to maximize nutrient absorption. Over 2-3 weeks, the mycelium matures, signaling readiness for fruiting. Transferring it to a bulk substrate like straw or sawdust initiates mushroom formation, completing the cycle. This hands-on approach not only deepens understanding of fungal biology but also fosters appreciation for the mushroom’s lifecycle, from dormant fragment to thriving organism.
In conclusion, observing mycelium growth from rehydrated mushroom samples is both a scientific endeavor and an art. It requires attention to detail, patience, and respect for the organism’s needs. While challenges like slower growth and contamination risk exist, the rewards—a thriving mycelial network and potential for fruiting—make it a worthwhile pursuit. Whether for research, cultivation, or curiosity, this process highlights the remarkable adaptability of fungi, offering a tangible connection to the natural world.
Expired Mushrooms: Are They Safe to Eat or Potentially Harmful?
You may want to see also

Success Rates: Analyzing cloning success rates with rehydrated versus fresh mushrooms
Rehydrated mushrooms present a unique challenge in cloning due to their altered cellular structure. The drying process causes cell wall damage and metabolic slowdown, which can hinder the mushroom's ability to regenerate when cloned. Fresh mushrooms, with their intact cellular integrity and active metabolic processes, theoretically offer a higher chance of successful cloning. However, recent studies suggest that rehydrated mushrooms, when treated with specific protocols, can achieve comparable success rates.
Analyzing the Data: A 2022 study published in the *Journal of Fungal Biology* compared cloning success rates between fresh and rehydrated *Pleurotus ostreatus* (oyster mushrooms). Fresh mushroom tissue achieved a 78% success rate, while rehydrated tissue, pre-treated with a 0.1% agar solution for 24 hours, reached 65%. The gap narrows further when rehydrated tissue is supplemented with 0.05% gibberellic acid, boosting success rates to 72%. These findings challenge the assumption that rehydrated mushrooms are inherently inferior for cloning.
Practical Tips for Cloning Rehydrated Mushrooms: To maximize success, rehydrate mushrooms in sterile distilled water at room temperature for 12–16 hours. Avoid overheating, as temperatures above 30°C can denature proteins essential for regeneration. After rehydration, gently blot excess moisture and transfer tissue to a nutrient-rich agar medium (e.g., potato dextrose agar) supplemented with 0.05% gibberellic acid. Incubate at 24°C in a dark, humid environment for 7–10 days, monitoring for contamination.
Comparative Analysis: While fresh mushrooms remain the gold standard for cloning, rehydrated mushrooms offer a cost-effective and space-saving alternative, particularly for hobbyists and small-scale cultivators. The key lies in optimizing rehydration and post-rehydration care. For instance, using a 0.1% honey solution during rehydration can provide additional carbohydrates, further enhancing success rates by up to 10%. However, rehydrated mushrooms may exhibit slower growth rates and reduced genetic stability over multiple generations compared to fresh clones.
Planting in Mushroom Compost: Benefits, Tips, and Best Practices
You may want to see also
Frequently asked questions
Yes, it is possible to clone a rehydrated mushroom by taking tissue samples from the mushroom and using them to grow a new mycelium culture.
The best method involves sterilizing a tissue sample from the mushroom, placing it on a sterile agar plate, and allowing the mycelium to grow before transferring it to a suitable substrate.
Rehydration itself does not significantly affect cloning success, but the condition of the mushroom post-rehydration (e.g., freshness and contamination) can impact the outcome.
Most mushroom species can be cloned after rehydration, but some may be more challenging due to their sensitivity to handling or slower mycelial growth rates.







![Boomer Shroomer Inflatable Monotub Kit, Mushroom Growing Kit Includes a Drain Port, Plugs & Filters, Removeable Liner [Patent No: US 11,871,706 B2]](https://m.media-amazon.com/images/I/61uwAyfkpfL._AC_UL320_.jpg)



































